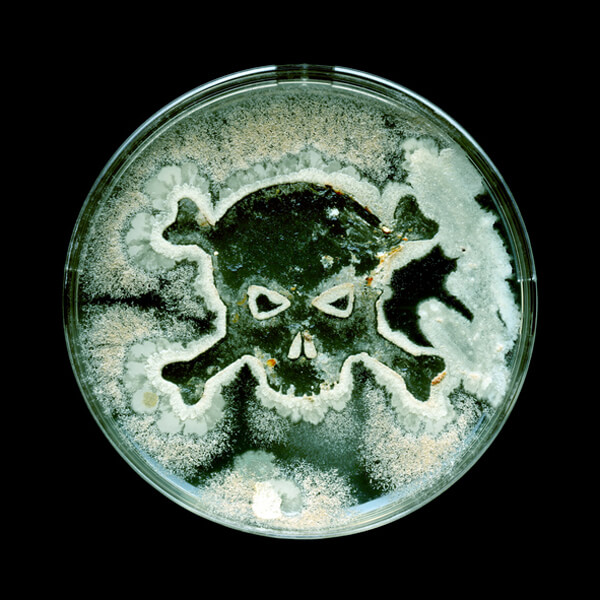

½Äǰ¿¡ ÇÉ °õÆÎÀÌ, ¶¼¾î ³»¸é ¸Ô¾îµµ ±¦ÂúÀ»±î?
±Û : ÀÌÇöÁÖ
°í¿Â´Ù½ÀÇÑ ³¯¾¾ÀÇ ¿©¸§Ã¶Àº ¹ú·¹ ȤÀº °õÆÎÀ̰¡ ¹ø½ÄÇÏ´Â µ¥ ÃÖÀûÀÇ È¯°æÀ» Á¶¼ºÇÑ´Ù. ÀÌ·Î ÀÎÇØ ½ÄǰÀ» ÀûÀýÇÏ°Ô º¸°üÇÏÁö ¾Ê¾Ò´Ù°¡ °õÆÎÀ̰¡ ³¢´Â ÀÏÀÌ ¹ß»ýÇϱ⠽±´Ù. ¿ì¸® ÁÖº¯ ½Äǰ¿¡¼ ÀÚÁÖ º¼ ¼ö ÀÖ´Â °õÆÎÀ̷δ »§À̳ª Ä¡Áî·ù¿¡ ÀÚÁÖ ÇÇ´Â Æä´Ï½Ç·ý, ´©·è°õÆÎÀÌÀÎ ¾Æ½ºÆä¸£±æ·ç½º, °úÀÏ¿¡¼ ÀÚÁÖ ¹ß»ýÇÏ´Â º¸Æ®¸®Æ¼½º µîÀÌ ÀÖ´Ù. °õÆÎÀÌ´Â ÁÖ·Î À¯Åë Áß ¿ë±â³ª Æ÷ÀåÁöÀÇ ÆÄ¼Õ ¶Ç´Â ±¸¸ÛÀÌ »ý°Ü ¿ÜºÎ °ø±â°¡ À¯À﵃ °æ¿ì ¹ß»ýÇÒ ¼ö ÀÖ´Ù. °õÆÎÀ̰¡ ÇÉ À½½Ä¹°À» À߸ø ¸ÔÀ¸¸é ½ÄÁßµ¶, ¹ÙÀÌ·¯½º¼º À§Àå¿°, ÀåÆ¼Çª½º, ÀÌÁú, ÄÝ·¹¶ó µî¿¡ °É¸± È®·üÀÌ ³ô´Ù. ÀÌ·¯ÇÑ °õÆÎÀÌ¿¡ ´ëóÇÏ´Â ¹æ¹ý¿¡´Â µÎ °¡Áö°¡ ÀÖ´Ù. À§»ý°Ç°»ó ±×³É ¹ö¸®´Â °æ¿ì¿Í °õÆÎÀÌ ºÎºÐ¸¸ ¶¼¾î ³»°í ¸Ô´Â °æ¿ì´Ù. °ú¿¬ ÀÌ µÎ °¡Áö ¹æ¹ý¸¸À¸·Î °õÆÎÀ̷κÎÅÍ °Ç°À» Áöų ¼ö ÀÖÀ»±î? Áö±ÝºÎÅÍ ¿©¸§Ã¶ °õÆÎÀÌ ´ëó¹ý¿¡ ´ëÇØ ÀÚ¼¼È÷ ¾Ë¾Æº¸µµ·Ï ÇÏÀÚ.
À½½Ä¹°¿¡ °õÆÎÀ̰¡ »ý±â´Â ÀÌÀ¯
°õÆÎÀÌ´Â ±Õ»ç·Î ÀÌ·ç¾îÁø »ý¹°ÀÇ ÇÑ ºÐ·ù·Î, µÎ²¨¿î ¼¼Æ÷º®À» °®°í ÀÖÀ¸¸ç ¾óÇÍ ½Ä¹°°ú ºñ½ÁÇÏÁö¸¸, ½º½º·Î ¾çºÐÀ» ¸¸µé¾î »ì¾Æ°¥ ¼ö ¾ø´Â Á¾¼Ó¿µ¾ç»ý¹°ÀÌ´Ù. °õÆÎÀÌ´Â ÁÖ·Î Æ÷ÀÚ Çü½ÄÀ¸·Î ¹ø½ÄÀ» ÇÑ´Ù. °õÆÎÀÌ Æ÷ÀÚ°¡ °ø±â Áß¿¡ ºÐ»êµÇ¾î ³¯¾Æ´Ù´Ï´Ù°¡ ¹ø½ÄÇϱâ ÁÁÀº ȯ°æÀÌ Á¶¼ºµÇ¸é, ±×°÷¿¡ ¾ÈÂøÇØ ±Õ»ç¸¦ »¸¾î ³ª°¡´Â °ÍÀÌ´Ù. ÁַΠź¼öȹ°°ú °°Àº ¿µ¾çºÐÀÌ Ç³ºÎÇÑ ½Äǰ¿¡ ±â»ýÇÏ¿© ¹ø½ÄÇϸç, À½½Ä¹°À» ½Ç¿Ü¿¡ ²¨³» ³õ¾ÒÀ» ¶§µµ Æ÷ÀÚ°¡ À½½Ä¹°¿¡ ¾ÈÂøÇØ ±â»ý ¹× ¹ø½ÄÀ» ÇÏ¸é¼ °õÆÎÀÌ·Î ÇǾ°Ô µÈ´Ù.

¹Ì±¹ ³ó¹«ºÎ USDA¿¡ µû¸£¸é ÅëÁ¶¸² ÇÜ, º£ÀÌÄÁ, ÇÖµµ±× ¼Ò½ÃÁö, Á¶¸®ÇÑ À½½Ä, ºÎµå·¯¿î Ä¡Áî, ¿ä±¸¸£Æ®, »ç¿öÅ©¸², ¶¥Äá¹öÅÍ, °ß°ú·ù, »§, Àë, Á©¸®, ¹«¸¥ °úÀÏÀ̳ª ä¼Ò µî ¼öºÐÀÌ ¸¹°í ¸»¶ûÇÑ À½½Ä¿¡ °õÆÎÀ̰¡ ¹ß»ýÇßÀ» °æ¿ì¿¡´Â °ú°¨È÷ ¹ö·Á¾ß ÇÑ´Ù. ´«¿¡ º¸ÀÌ´Â ºÎºÐ ¿Ü¿¡µµ °õÆÎÀ̰¡ ÆÛÁ® ÀÖÀ» °¡´É¼ºÀÌ Å©¸ç, À°·ùÀÇ °æ¿ì °õÆÎÀÌ¿Í ÇÔ²² ¹ÚÅ׸®¾Æ°¡ ÀÚ¶ó ÀÖÀ» ¼öµµ Àֱ⠶§¹®ÀÌ´Ù. ƯÈ÷ Àë¿¡¼ ÇÇ¾î³ °õÆÎÀÌ´Â °õÆÎÀÌ µ¶¼Ò¸¦ ÇÔÀ¯Çϰí ÀÖÀ» °¡´É¼ºÀÌ ³ôÀ¸¹Ç·Î Åë°·Î ¹ö¸± °ÍÀ» ±ÇÇÑ´Ù.
°õÆÎÀÌ ºÎºÐÀ» Á¦°ÅÇϰí
¸Ô¾îµµ µÇ´Â ½Äǰ
»ì¶ó¹Ì ¼Ò½ÃÁö, ¹«¸£Áö ¾ÊÀº Ä¡Áî, ¾ç¹èÃß, ÇǸÁ, ´ç±Ù µîÀÇ Ã»°ú¹°Àº ´Ü´ÜÇÏ°í ±¸Á¶°¡ Ä¡¹ÐÇÏ¿© °õÆÎÀ̰¡ ±íÀÌ Ä§ÅõÇÏ±â ¾î·Æ±â ¶§¹®¿¡, °õÆÎÀ̰¡ »ý±ä ºÎÀ§¸¦ ±âÁØÀ¸·Î 1ÀÎÄ¡(2.5cm) ÀÌ»ó ¶³¾îÁø ºÎºÐ±îÁö ÀÚ¸£°í ÆÄ³»¸é ºñ±³Àû ¾ÈÀüÇÏ°Ô ¼·Ãë °¡´ÉÇÏ´Ù. ÇÏÁö¸¸ °õÆÎÀ̰¡ ÇÉ À½½ÄÀº ÇØ´ç ºÎºÐÀ» ±í°Ô µµ·Á³Â´Ù ÇÏ´õ¶óµµ °õÆÎÀ̰¡ ¾ó¸¶¸¸Å ÆÛÁ® ÀÖ´ÂÁö ´«À¸·Î Á¤È®È÷ È®ÀÎÇÒ ¼ö ¾ø±â¿¡ ´Ü´ÜÇÑ À½½ÄÀÏÁö¶óµµ µÇµµ·Ï ¸ÔÁö ¾Ê´Â °Ô ÁÁ´Ù.
°õÆÎÀ̰¡ °Ç°¿¡ ¹ÌÄ¡´Â ¿µÇâ
¸é¿ª·ÂÀÌ ÃæºÐÇÑ »ç¶÷ÀÇ °æ¿ì °õÆÎÀ̰¡ ÇÉ À½½ÄÀ» ÇÑ ¹ø ¼·ÃëÇÑ´Ù°í ÇØµµ °Ç°»ó Å« ¹®Á¦°¡ ÀϾÁö ¾Ê´Â´Ù. ±×·¯³ª ¸é¿ª·ÂÀÌ ¾àÇϰųª ¸¸¼ºÁúȯ, õ½Ä, ¾Ë·¹¸£±â µîÀÇ ¹®Á¦°¡ ÀÖ´Â »ç¶÷ÀÇ °æ¿ì °õÆÎÀ̰¡ ¼Òȱâ°è³ª È£Èí±â°è µî¿¡ ½É°¢ÇÑ ¿µÇâÀ» ¹ÌÄ¥ ¼öµµ ÀÖ´Ù. ¸¸¾à °õÆÎÀ̰¡ ÇÉ À½½ÄÀ» ½Ç¼ö·Î ¸Ô¾ú°Å³ª °õÆÎÀ̸¦ Á¦°ÅÇÑ µÚ À½½ÄÀ» ¸Ô¾ú´Âµ¥ ±¸¿ªÁú, ±¸Åä, ¿, Çö±âÁõ, ¼³»ç, µÎÅë µîÀÇ Áõ»óÀÌ ³ªÅ¸³´Ù¸é ¹Ýµå½Ã º´¿ø¿¡ ¹æ¹®ÇØ¾ß ÇÑ´Ù.

´ëºÎºÐÀÇ °õÆÎÀÌ´Â ¹«ÇØÇÏÁö¸¸ ÀϺδ À§ÇèÇÑ µ¶¼Ò¸¦ °®°í ÀÖ´Ù. ±× Áß ´ëÇ¥ÀûÀÎ ¾ÆÇöóÅå½Å(aflatoxin)Àº ¾ÏÀ» À¯¹ßÇÏ´Â µ¶¼Ò·Î ¾Ë·ÁÁ® ÀÖ¾î Æ¯È÷ Á¶½ÉÇØ¾ß ÇÒ Çʿ䰡 ÀÖ´Ù. °õÆÎÀÌ µ¶¼Ò´Â ´ëºÎºÐ °î¹°À̳ª °ß°ú·ùÀÇ °õÆÎÀÌ¿¡¼ ¹ß°ßµÇÁö¸¸ Æ÷µµÁÖ½º, »ø·¯¸®, »ç°ú µîÀÇ ´Ù¸¥ ½Äǰ¿¡¼µµ ¹ß»ýÇÒ ¼ö ÀÖ´Ù. ¸¸¾à ƯÁ¤ °õÆÎÀÌ µ¶¼Ò¸¦ Àڽŵµ ¸ð¸£´Â »çÀÌ¿¡ ¿À·£ ±â°£ ¼·ÃëÇÏ°Ô µÈ´Ù¸é, °£¾Ï µî ½É°¢ÇÑ »óÅ¿¡ À̸¦ ¼ö ÀÖ´Ù.
°õÆÎÀ̸¦ ¸·´Â ¹æ¹ý
°õÆÎÀÌ´Â ³·Àº ¿Âµµ¿¡¼µµ ¹ø½Ä »ýÁ¸·ÂÀÌ Àֱ⠶§¹®¿¡ ³ÃÀå°í ¾È¿¡¼µµ ÀÚ¶ö ¼ö ÀÖ´Ù. ±×»Ó ¾Æ´Ï¶ó ¼Ò±ÝÀ¸·Î ÀýÀΠ§ »óųª ¼³ÅÁÀ¸·Î ÀýÀÎ ´Ü »óÅÂ, »ê¼ºÀÇ È¯°æ¿¡¼µµ ¹ß»ýÇÒ ¼ö ÀÖ´Ù. °õÆÎÀÌ Æ÷ÀÚÀÇ ¹ø½ÄÀ» ÃÖ´ëÇÑ ¸·±â À§Çؼ´Â À½½Ä¹°ÀÇ ½Å¼±ÇÔÀ» À¯ÁöÇÒ ¼ö ÀÖµµ·Ï ÀûÀýÇÑ º¸°ü¿ë±â¸¦ »ç¿ëÇϰí, Ç×»ó ¶Ñ²±À» Àß ´Ý¾Æ¾ß Çϸç, ÀÏ´Ü °³ºÀÇÑ ½ÄǰÀº 3~4ÀÏ À̳»¿¡ ó¸®ÇØ¾ß ÇÑ´Ù. ³ÃÀå°íµµ ÁÖ±âÀûÀ¸·Î û¼Ò ¹× Á¤¸®¸¦ ÇØ ÁÖ¾î¾ß ÇÑ´Ù.
°õÆÎÀÌ ÇÉ À½½Ä °¡¿ÇÏ¸é ±¦ÂúÀ»±î?
°õÆÎÀ̰¡ »ý±ä À½½ÄÀ» µ¥¿ì°Å³ª ²ú¿© ¸ÔÀ¸¸é °ú¿¬ ¾ÈÀüÇÒ±î? ½ÄǰÀǾàǰ¾ÈÀüó¿¡ µû¸£¸é ´ëºÎºÐÀÇ °õÆÎÀÌ µ¶¼ÒµéÀº ¿¿¡ ¸Å¿ì °ÇØ °¡¿À» ÇÑ´Ù°í ÇØ¼ ¿ÏÀüÈ÷ ¾ø¾îÁöÁö ¾Ê´Â´Ù. ƯÈ÷ °õÆÎÀÌ µ¶¼Ò Áß ÇϳªÀΠǪ¸ð´Ï½ÅÀº ÁÖ·Î ¿Á¼ö¼ö, ¹Ð°ú ½Ò µî¿¡¼ »ý±â´Âµ¥, Ǫ¸ð´Ï½ÅÀº 100¡É·Î °¡¿Çصµ »ç¶óÁöÁö ¾Ê´Â´Ù°í ÇÑ´Ù. Àß ¾Ë·ÁÁø °õÆÎÀÌ µ¶¼Òµé Áß ÆÄÅø¸°¸¸ÀÌ °¡¿ °úÁ¤À» ÅëÇØ ±× ¼öÁØÀÌ °¨¼ÒµÉ ¼ö ÀÖ´Ù. ¾Æ¹«Æ° °õÆÎÀ̰¡ »ý±ä ½ÄǰÀº µÇµµ·ÏÀÌ¸é ¸ÔÁö ¾Ê´Â °Ô ÁÁ´Ù.
¸ö¿¡ ÁÁÀº °õÆÎÀ̵µ ÀÖÀ»±î?
°õÆÎÀ̱ÕÀÌ ²À °Ç°¿¡ ÇØ·Î¿î °Í¸¸Àº ¾Æ´Ï´Ù. °õÆÎÀ̱ÕÀÇ ÀÏÁ¾ÀÎ È¿¸ð±ÕÀ̳ª Æ÷ÀÚ±Õ, °íÃÊ±Õ µîÀº ¿ÀÈ÷·Á °Ç°¿¡ À̷οî ÀÛ¿ëÀ» ÇÏ´Â °ÍÀ¸·Î ¾Ë·ÁÁ® ÀÖ´Ù. ÀÌµé °õÆÎÀÌ´Â ¿ì¸® ¸ö¿¡ À̷οî ÀÛ¿ëÀ» ÇÏ´Â ÇÁ·Î¹ÙÀÌ¿Àƽ½ºÀÇ ÇÑ Á¾·ù´Ù. Æ÷ÀÚ±ÕÀ̳ª È¿¸ð±ÕÀ» ²ÙÁØÈ÷ ¼·ÃëÇÏ¸é ¸é¿ª·Â¿¡ ÁÁÀº ¿µÇâÀ» ¹ÌÄ¥ »Ó ¾Æ´Ï¶ó °ú¹Î¼º ´ëÀåÁõÈıº, ¿°Áõ¼º Áúȯ µî ´ëÀå Àå¾Ö Áõ»óÀ» ¿ÏÈÇÏ°í °³¼±ÇÏ´Â µ¥ µµ¿òÀ» ¹ÞÀ» ¼ö ÀÖ´Ù. ¿ì¸®³ª¶ó ´ëÇ¥ À½½ÄÀÎ °íÃßÀå, µÈÀå, ±èÄ¡, Á£°¥, ¸·°É¸® ¸ðµÎ È¿¸ð±Õ¿¡ ÀÇÇÑ ¹ßÈ¿À½½ÄÀÌ´Ù.

¾î¶»°Ô Á¦°ÅÇϳª?
À帶öÀÌ °ãÄ¡¸é À½½Ä¹°»Ó ¾Æ´Ï¶ó º®Áö, ÁÖ¹æ ÇÒ °Í ¾øÀÌ Áý¾È °÷°÷¿¡ °õÆÎÀÌ·Î °¡µæÇÏ´Ù. °õÆÎÀÌ´Â ½ÀÇÑ °ø±â¿Í °ü·ÃÀÌ Å©¹Ç·Î À̸¦ ¸·À¸·Á¸é ÇÏ·ç¿¡ 2¹ø ÀÌ»óÀº ȯ±â¸¦ ½ÃÄÑ¾ß ÇÑ´Ù. ½Àµµ´Â 60~80% Á¤µµ·Î À¯ÁöÇØ¾ß Çϸç, ½Ç³»¸¦ ³Ê¹« ´þ°Ô ³öµÎ´Â °Íµµ ÇÇÇØ¾ß ÇÑ´Ù. ¼ÒÆÄ³ª Ŀư µî¿¡ ³»·Á¾ÉÀº ¸ÕÁö´Â ÀÚÁÖ Á¦°ÅÇØ ÁÖ´Â °ÍÀÌ ÁÁ°í, ¼Ò·®ÀÇ ¾ËÄÚ¿ÃÀ» »Ñ·Á ÁÖ´Â °Íµµ °õÆÎÀÌ ¹ø½Ä ¾ïÁ¦¿¡ È¿°úÀûÀÌ´Ù. °õÆÎÀ̰¡ Àß »ý±â´Â º£¶õ´Ù â¹® Æ´»õ³ª ÈÀå½Çµµ ÀÚÁÖ Ã»¼ÒÇÏ°í ¹°±â¸¦ Á¦°ÅÇØ Áà¾ß ÇÑ´Ù.
ÇǺÎÁúȯÀÇ ÁÖ¹ü,
°õÆÎÀ̸¦ ¸·´Â »ýȰ¼öÄ¢
½Ç³» °ø±â °ü¸®¿Í û¼Òµµ Áß¿äÇÏÁö¸¸ °¢Á¾ ÇǺÎÁúȯÀ» ¿¹¹æÇϱâ À§Çؼ´Â °³ÀÎ À§»ý °ü¸®µµ ¸Å¿ì Áß¿äÇÏ´Ù. ½Åü ºÎÀ§ Áß °Üµå¶ûÀ̳ª »çŸ±¸´Ï µî ¶¡ÀÌ Àß ³ª°í ½ÀÇÑ ºÎÀ§´Â ´õ¿í´õ ½Å°æ ½á¼ ¾Ä¾î ÁÖ´Â °ÍÀÌ ÇÊ¿äÇϰí, ´õ¿ï¼ö·Ï ÅëdzÀÌ ÀߵǴ ¿ÊÀ» ÀÔ´Â °Íµµ Å« µµ¿òÀÌ µÈ´Ù. ½Å¹ß ¿ª½Ã ³Ê¹« ²Ë Á¶ÀÌ´Â °ÍÀº ¹«Á»À̳ª °õÆÎÀÌ±Õ °¨¿°À» ÀÏÀ¸Å³ ¼ö ÀÖÀ¸´Ï ÁÖÀÇÇØ¾ß ÇÑ´Ù. ¶¡À̳ª ¼¼Å¹ ÈÄ ¹°¿¡ Á¥Àº ÀÇ·ù´Â È®½ÇÇÏ°Ô °ÇÁ¶ ÈÄ ÀÌ¿ëÇϵµ·Ï ÇÏÀÚ.
ÀÌÇöÁÖ press@daily.co.kr
¸ÂÃãÇü ÃÖÀú°¡ Á¤º¸
ÀúÀÛ±ÇÀÚ ¨Ï µ¥Àϸ®. ¹«´ÜÀüÀç ¹× Àç¹èÆ÷ ±ÝÁö.
¼Ò¼È °èÁ¤ ·Î±×ÀÎÀ¸·Î °£ÆíÇÏ°Ô ´ñ±ÛÀ» ³²°Üº¸¼¼¿ä!
¿øº» À̹ÌÁöÀÔ´Ï´Ù.
µÎ ¼Õ°¡¶ôÀ» ÀÌ¿ëÇØ À̹ÌÁö¸¦
È®´ë ¶Ç´Â Ãà¼ÒÇÏ½Ç ¼ö ÀÖ½À´Ï´Ù.